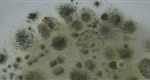

Toepassingen, projecten
Hieronder een aantal leuke toepassingen van sensoren en andere hardware.
Met beschrijvingen en eventuele schema’s.
Er zijn momenteel 15 toepassingen beschreven.
Communicatie tussen Arduino’s middels I2C
Communicatie tussen Arduino’s middels I2C Omschrijving Je kan meerdere I2C Modulen, sensoren op de I2C bus aansluiten, vermits ze een uniek adres hebben. Neem bijv. BME280 (Hygro-, baro-, temperatuur sensor), Memory chips, display’s ect. Ook een Arduino kan werken als zo’n I2C component. Het voordeel is, dat je hem ook een adres kan geven.Bij deze […]
Aangemaakt op: 13-11-2025 17:56
Big display met neopixels (44 led’s)
Big display met neopixels (44 led’s) De bouw Ik heb een lat laminaat gebruikt omdat het stevig was. Een klein plankje gemaakt voor 2 cijfers en de dubbele punt. Met behulp van een display sjabloon ben ik de segmenten gaan uitzagen met een figuur zaag. Spuiten met zilver verf, daarna plak folie eroverheen met een […]
Aangemaakt op: 13-11-2025 11:41
USB toetsenbord op Arduino
USB toetsenbord op Arduino Omschrijving Het is mogelijk om een USB toetsenbord op een Arduino aan te sluiten zonder dat de Arduino een extra USB aansluiting heeft.Ik heb getest met een Arduino Nano. Je kan er een USB A, USB mini, USB Micro en USB C aansluiting op maken. Allen hebben een D- (data) en […]
Aangemaakt op: 13-11-2025 10:59
Eenvoudige Robot arm
Eenvoudige Robot arm Omschrijving Deze Robot arm bestaat uit 4 servo motoren en een bouwpakket. Frame Servo MG90S Het is een leerzaam project, om een robot arm goed aan te sturen.Ik het software voorbeeld onder downloads vind je een voorbeeld. Met 4 potmeters kan je eenvoudig de servo’s aansturen, via de debug mode kan je […]
Aangemaakt op: 12-11-2025 20:27
LED-CUBE (4x4x4)
LED-CUBE (4x4x4) Omschrijving 3D led kubus blauw voor arduino, 64 kubusvormige LED’s en bestuurd door Arduino. Dit arduino shield maakt gebruik van twee 74HC595 schuifregister chips, met acht I/O’s kan de 4x4x4 Light Cube worden verlicht, de benodigde pinnen zijn minder dan bij andere 4x4x4 lichte kubieke uitbreidingskaarten (heeft 20 I/O’s nodig om te bedienen). […]
Aangemaakt op: 11-11-2025 18:31
Arduino Due kan printen, hoe…
Arduino Due kan printen, hoe… (via Centronics poort) Benodigdheden Arduino due Level shifters, 3,3V <–> 5 V Zie ook BSS138 4-ch level shifter Test board 2 weerstanden 5k6 Flatcable Centronics Printer (DPU20-20CF) Onderdelen in detail Adrduino DUE Test board Centronics printer (her de DPU20-20CF) Tussenkabel voor de printer te koppelen met het testboard Ontwerp aansluit […]
Aangemaakt op: 11-11-2025 11:15
Verbetering op de ‘ultrasone mist maker’
Verbetering op de ‘ultrasone mist maker’ Algemeen Het doel is om zolang mogelijk mist te produceren. Dus de water voorraad moet voldoende zijn, en het poëtisch element met het water in aanraking blijven. Dus als je een katoenen lont maakt die het water opzuigt (capillaire werking), dan blijft het einde vochtig. Vochtig genoeg om het […]
Aangemaakt op: 08-11-2025 21:05
Een andere Arduino stuurt de Ihto afzuigsysteem aan.
Een andere Arduino stuurt de Ihto afzuigsysteem aan. Voeg uw header hier toe Dit test projectje is gemaakt met een hygrometer sensor DHT22 en de Arduino ‘SP8266 NodeMcu V3 Lua’.Als de vochtigheidsgraad boven een ingestelde waarde komt, stuurt deze Arduino een commando naar de Arduino home automation module.Die op zijn beurt het centrale afzuigsysteem aanstuurt. […]
Aangemaakt op: 08-11-2025 20:50
De DHT22 (hygro sensor) en de Ultrasone mist maker samen
De DHT22 (hygro sensor) en de Ultrasone mist maker samen Omschrijving Een goede luchtvochtigheid in een kamer is erg belangrijk voor een gezonde leef omgeving. Dit is een prototype opstelling om automatisch de luchtvochtigheid in in een kamer te regelen. Dit maar met 2 componenten en 1 Arduino NANO. Hoe werkt het De opstelling heeft 1 […]
Aangemaakt op: 08-11-2025 20:24
Arduino schimmel kans meter
Arduino schimmel kans meter Omschrijving Een verdere ontwikkeling op basis van Barometer (BMP 085) en Hygrometer (HYT-221) sensoren. Zie Een mogelijkheid om schimmelvorming te voorkomen in bepaalde ruimten. (Douche)Je hebt hiervoor nodig: Hygrometer sensor 2 temperatuur sensoren Ik gebruik voor de Hygrometer / temperatuur sensor de HYT-221, en voor de losse temperatuur sensor de DHT22 (alleen het temperatuur deel). […]
Aangemaakt op: 07-11-2025 20:03
- Fri 07 November 2025